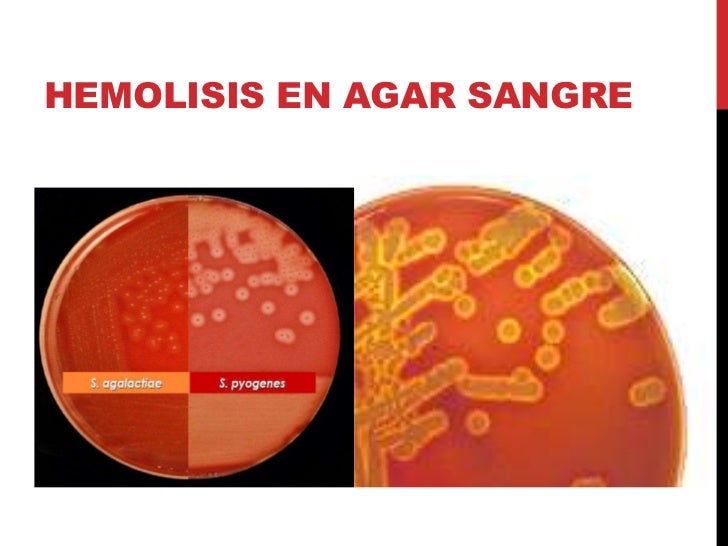

Blood Agar Alpha Beta Gamma

Este medio de cultivo se compone básicamente de un agar base enriquecido y 5% de sangre ovina. La base de agar puede variar de acuerdo a las necesidades, pero principalmente estará compuesto por peptonas, aminoácidos, vitaminas, extracto de carne, cloruro de sodio, agar, entre otros. En cuanto a la sangre, en ocasiones se usa sangre humana.
AGAR SANGRE AGAR SANGRE MEDIO DE CULTIVO TIPOS DE HEMÓLISIS AGAR SANGRE Agar sangre

Hemólisis alfa. Este tipo de hemólisis se caracteriza por un aspecto verdoso o ligeramente turbio en la placa de agar sangre. Es causado por bacterias que producen enzimas llamadas hemolisinas, las cuales destruyen parcialmente los glóbulos rojos. Aunque la hemólisis alfa no produce una destrucción total de los glóbulos rojos, sí causa.
Placa de agar sangre beta hemolisis fotografías e imágenes de alta resolución Alamy

Discusión. La primera variable estudiada como factor de hemólisis fue el tipo de punción. El 2% de hemólisis en las muestras extraídas mediante venopunción directa con aguja confirma esta técnica como la de menor tasa de hemólisis, lo que contrasta con el bajo número de este tipo de extracciones, sólo el 18%.
Introducción a la microbiología
Streptococcus pneumoniae creciendo en agar columbia nutrido con sangre de caballo. Hemólisis alfa. Cepa mucoide aislada de la conjuntiva de un niño de seis semanas de edad. El agar sangre es una combinación de un agar base (agar nutritivo) con el agregado de 5 % de sangre ovina, [1] también puede usarse sangre humana, para cultivos en una placa de Agar.
BLOOD AGAR Microbiology Laboratory Turkey

TECNOLOGÍA MÉDICA - UNIVERSIDAD SAN SEBASTIAN CONCEPCIÓN 2023 1 HEMÓLISIS ¿QUÉ ES LA ALFA HEMOLISIS? La hemólisis alfa es un tipo de reacción que puede ocurrir en ciertas bacterias, especialmente en el género Streptococcus.
Halos de hemólisis en agar suplementado con sangre de carnero,... Download Scientific Diagram

La hemólisis (del griego αιμόλυση, que significa 'descomposición de la sangre') es la descomposición de los glóbulos rojos . La capacidad de las colonias bacterianas para inducir hemólisis cuando se cultivan en agar sangre se utiliza para clasificar ciertos microorganismos . Esto es particularmente útil para clasificar las especies de estreptococos .
Blood Agar Plate Dan Uji Hemolisi

El agar sangre es un medio de cultivo muy utilizado. El agar sangre composición es de suma importancia para saber como funciona, además los tipos de hemólisi.
Docencia Microbiología UMHCapacidad hemolítica Prácticas Microbiología UMH

El agar sangre es especialmente adecuado para la determinación de la hemólisis. La hemólisis es la ruptura de la membrana de los glóbulos rojos por una proteína bacteriana conocida como hemolisina, que provoca la liberación de hemoglobina de los glóbulos rojos celda. Muchos tipos de bacterias poseen proteínas hemolíticas.
1件の「Blood agar shows gamma hemolysis」の画像、写真素材、ベクター画像 Shutterstock

Capacidad hemolítica. Fundamento. Muchos microorganismos son capaces de crecer en agar sangre y cuando lo hacen responden de diferente manera según realicen o no la lisis de los glóbulos rojos (hemólisis) producida por la acción de una enzima llamada hemolisina. Podemos diferenciar tres tipos de hemólisis: Hemólisis alfa.
hemolysis on blood agar YouTube

Uso y aplicaciones clínicas: El agar sangre se utiliza ampliamente en el laboratorio clínico para el aislamiento, identificación y caracterización de microorganismos presentes en muestras biológicas. Algunas de las aplicaciones más comunes incluyen: Diagnóstico de infecciones bacterianas, como bacteriemias, endocarditis, neumonías y.
Beta and gammahemolysis of Pseudomonas aeruginosa on blood agar.

Hemólisis alfa: La hemólisis alfa se refiere a la decoloración verdosa y la hemólisis parcial de los glóbulos rojos que rodean las colonias de algunos estreptococos en placas de agar de sangre. Hemólisis Beta: La hemólisis beta se refiere a la descomposición completa de los glóbulos rojos demostrada por una zona clara que rodea la.
Hemólisis producida por A. hydrophila en agar BHI suplementado con sangre Download Scientific

TAXONOMIA BACTERIOLOGICA BASICA. AGAR SANGRE. HEMOLISIS. Medio de cultivo enriquecido con la adicción de sangre. Las hemolisinas son enzimas que lisan los hematíes. Las bacterias que producen estas enzimas presentan un halo transparente alrededor de las colonias a consecuencia de la lisis de los hematíes. Se siembre por agotamiento en.
Beta Hemolysis on Blood Agar RigobertotaroGreene

Podemos diferenciar tres tipos de hemólisis: Hemólisis alfa: es una hemólisis parcial y la zona de crecimiento aparece rodeada de un halo de color verdoso. Hemólisis beta: en este caso la hemólisis es total y el halo que rodea a las colonias es totalmente transparente. Hemólisis gamma (no hemólisis): el microorganismo en cuestión no es.
Halos de hemólisis en agar suplementado con sangre de carnero,... Download Scientific Diagram

siembre por agotamiento en estría en placas de agar sangre y se incuba. Hemólisis alfa. Hemólisis beta. Hemólisis gamma. La hemólisis alfa se refiere a una lisis parcial de eritrocitos que produce una coloración verde que se observa alrededor de las colonias (debido a la liberación de un producto de degradación de la hemoglobina llamado bili-, 8/7/2019 · globulos rojos hemolisina.
Tipos de hemólisis (lisis de los eritrocitos) en agar sangre A) alfa hemólisis

Capacidad hemolítica. Fundamento. Muchos microorganismos son capaces de crecer en agar sangre y cuando lo hacen responden de diferente manera según realicen o no la lisis de los glóbulos rojos (hemólisis) producida por la acción de una enzima llamada hemolisina. Podemos diferenciar tres tipos de hemólisis: Hemólisis alfa.
Beta hemólisis en Agar Sangre YouTube

Agar sangre: fundamento, usos y preparación. El agar sangre es un medio de cultivo sólido enriquecido, diferencial pero no selectivo. Es utilizado para la recuperación y crecimiento de una gran variedad de microorganismos provenientes de muestras clínicas o para subcultivos. El agar sangre clásico debe ser incluido para el sembrado de la.
.